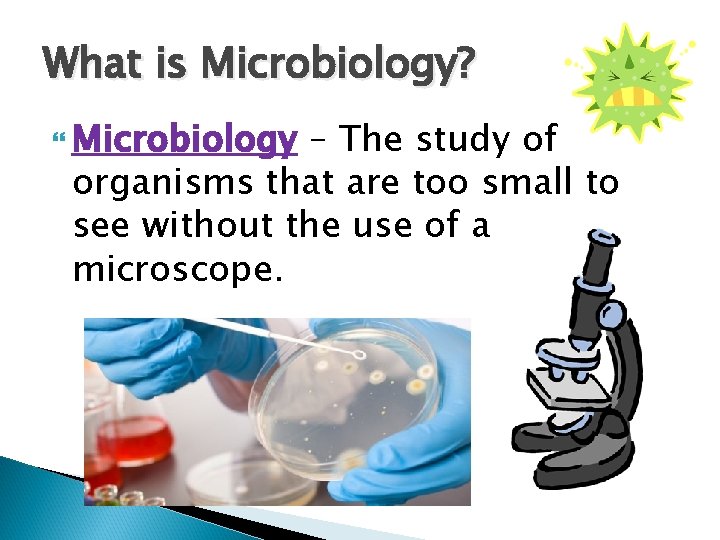
What is Microbiology? Microbiology – The study of organisms that are too small to

Microbiology Parasites Viruses Bacteria Fungus Vocabulary Activity Work

Microbiology Parasites Viruses Bacteria Fungus

Vocabulary Activity Work together with your table partner to match the roots (prefixes/suffixes) and their meaning. Once you are finished, brainstorm with your partner about what words you know that contain the same roots. Make a list of words on a scratch sheet of paper.
What is Microbiology? Microbiology – The study of organisms that are too small to see without the use of a microscope.

Microbiology Vocabulary Unicellular – An organism made of only one cell. Uni = one Multicellular – An organism made of more than one cell. Multi = more than one (many)

Microbiology Vocabulary Prokaryote – Any singlecelled organism that does NOT have a nucleus. Pro = First/Before Eukaryote – Any organism whose cells have a true nucleus. Eu= True/Good

Microbiology Vocabulary Autotroph – An organism that makes it’s own food. Auto = Self Heterotroph – An organism that eats different organisms. ◦ Hetero = Different

What causes disease? Pathogen– Any organism that causes a disease. Examples: ◦ 1. Parasites ◦ 2. Fungus ◦ 3. Bacteria ◦ 4. Viruses

Parasites Parasite - an organism that lives on or in a host and causes harm to the host. ◦ Parasite Characteristics: ◦ Multicellular ◦ Eukaryote ◦ Heterotroph

Parasites Examples: Tapeworms, Pinworms, Hookworms, Lice, and many more…

Protozoan Parasite A protozoan parasite called Plasmodium causes the disease malaria. It can have two hosts, mosquitoes and humans. *Other Protozoans include Amoeba, Paramecium, and Euglena Proto= First and Zoa= Animal

Parasitic Diseases Parasites can cause disease in humans. Examples: ◦ Trichinosis ◦ Scabies ◦ Toxoplasmosis ◦ Malaria

Parasite Videos Monsters Inside Me http: //animal. discovery. com/videos/monster s-inside-me-pork-tapeworm-in-brain. html http: //www. dailymotion. com/video/x 17 ha 6 y _monsters-inside-me-s 03 e 03 -my-faceeating-parasite_lifestyle http: //www. dailymotion. com/video/x 17 ywuc _monsters-inside-me-s 03 e 07 -i-coughed-up -worms_lifestyle

Fungus

“There is a Fungus among us!” Fungus Characteristics: ◦ Multicellular ◦ Eukaryote ◦ Heterotroph ◦ Needs a warm and moist environment in order to survive!

Parts of a Fungus Fungi are made up of Hyphae, branching threadlike tubes.

How do Fungi eat? 1. Uses the hyphae to grow into their food 2. Oozes digestive chemicals into the food 3. Chemicals break down the food so it can be absorbed by the fungus. Ex: Mold growing on an orange.

Diseases caused by Fungus Athlete’s Foot Candidiasis (“Thrush”) Ringworm Fungal Eye Infections *Fungus can be treated and killed with Antifungal creams and sprays.

How do Fungi reproduce? Fungi release spores into the environment. The cap of the mushroom releases the spores

Fungus Lab You will work with your NEW Lab Group. Choose jobs and read the procedure. Be sure to make the cotton ball pieces small (roll into balls with your fingers) before you put it in the balloon. Share tape with a lab group next to you. For the LAST step, come see me and the fan in the front of the room.
- Slides: 19